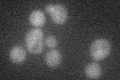
YGL190C
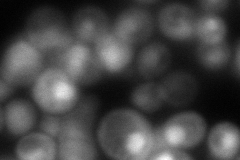
YGL190C
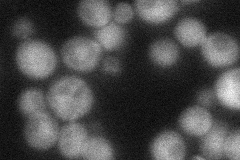
YGL190C
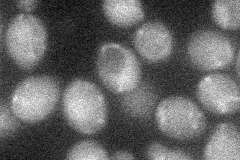
YGL190C
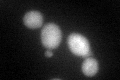
YGL190C
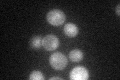
YGL190C

View description
Non-essential regulatory subunit B of protein phosphatase 2A (PP2A), which has multiple roles in mitosis and protein biosynthesis; involved in regulation of mitotic exit; found in the nucleus of most cells, also at bud neck and bud tip
Localization:
Intensity:
Fold change:
Significance:
-
C’ GFP library in SD
cytosol31.35 -
N' NOP1pr-GFP in SD

cytosol,nucleus59.8147 -
N' TEF2pr-mCherry in SD
cytosol,nucleus24.6479 -
N' NATIVEpr-GFP in SD
cytosol41.7735 -
N' TEF2pr-VC and Cyto-VN in SD
cytosol28.157 -
C’ GFP library in SD+DTT
cytosol37.261.18No -
C’ GFP library in SD+H2O2

cytosol37.091.18No -
C’ GFP library in Starvation Media
nucleusN/AN/AYes -
C’ GFP library on the background of Pup2-DaMP

cytosol -
C’ GFP library on the background of CCT mutant

cytosol34.55791.10199No
